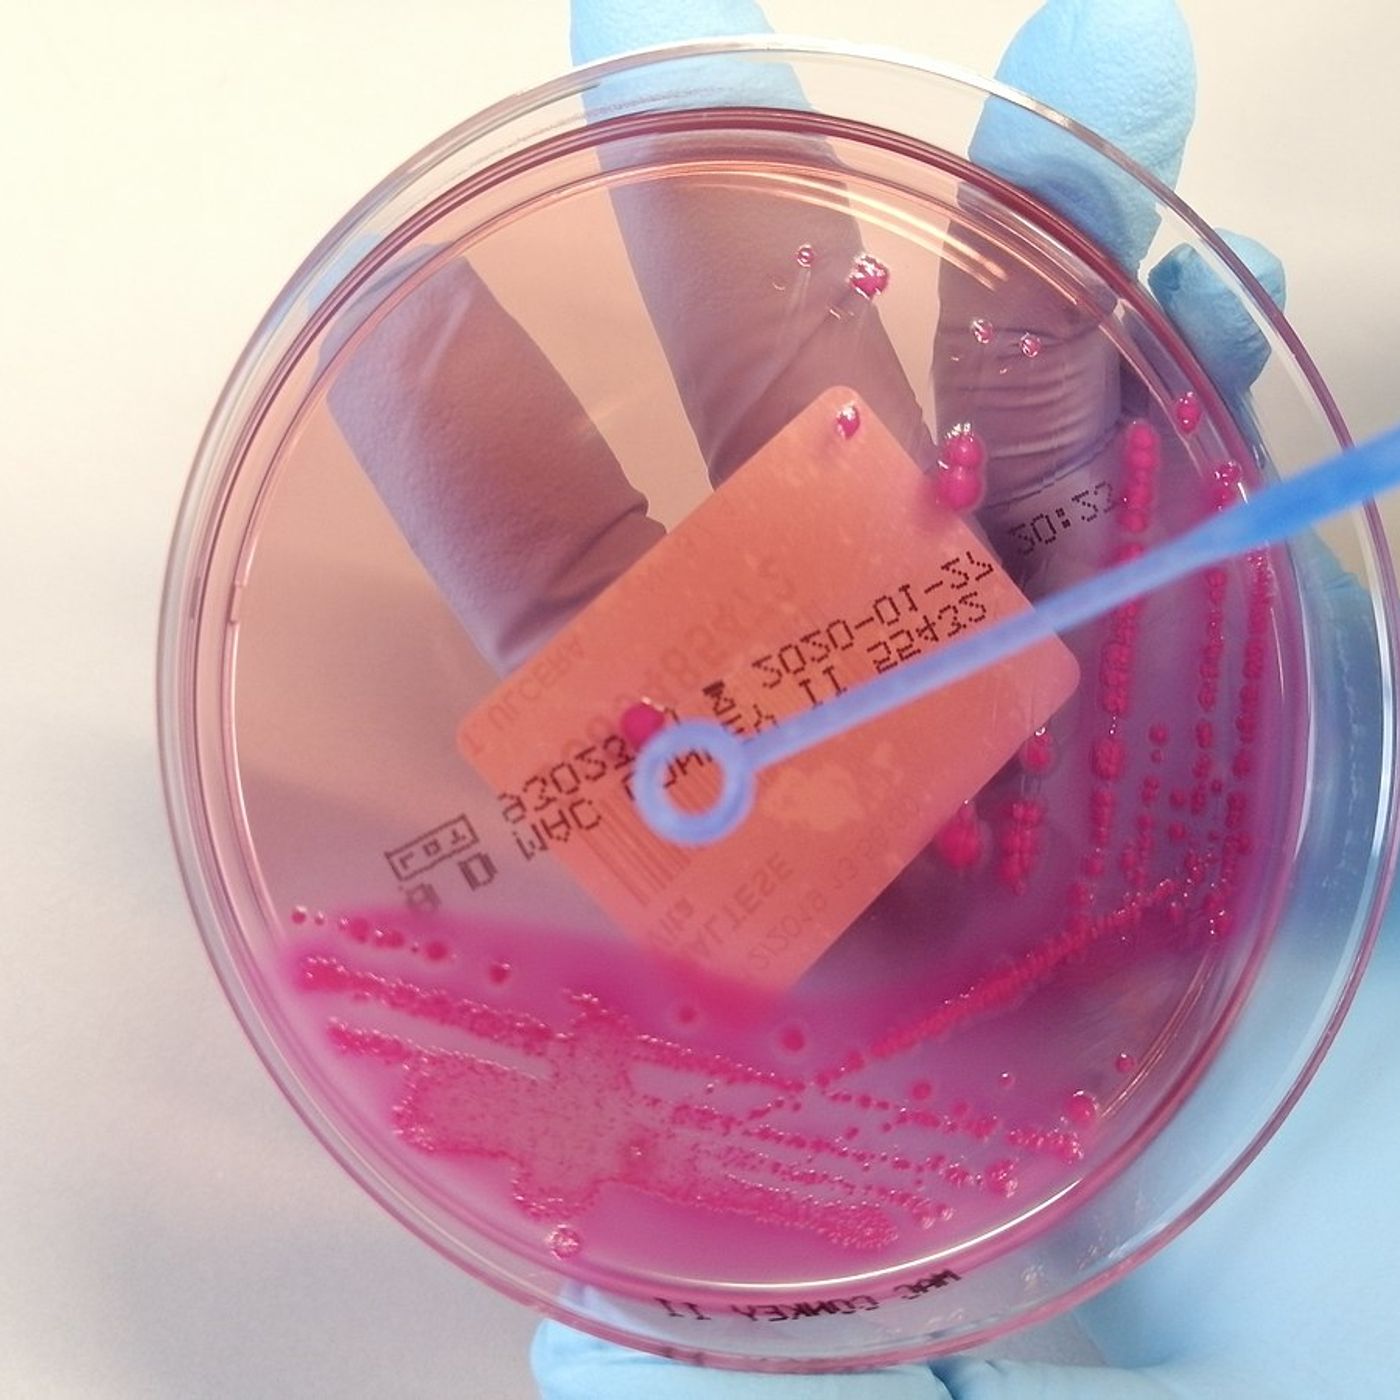

Episode 82: All-Star Selections and the Petri Dish East
Raptors Reddit PodcastFeb 26, 2021 • 1:02:00
Play Episode
Episode Notes
On this week’’s episode we discuss the Eastern Conference All-Star Selection. Were the Raptors snubbed? Who were the most questionable selections? Should FVV have made the game over Simmons, Randle or even Tatum? We reminisce about the good old days of all-star selection by hand at the arena. The Raptors continue to be plagued by defensive adjustments and does Nurse need to innovate his defense more for the Raptors to hit another level? We breakdown the recent loss to the Heat and explore the limitations of the roster beyond the top seven. Lastly we discuss the top post from the Raptors Reddit community including Boucher coming to Yuta’’s rescue and Finch being hired as the new T-Wolves coach.








